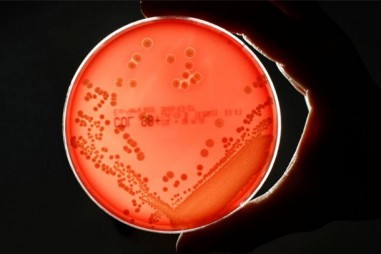
Siêu vi khuẩn HP gây ung thư đã trở nên khó diệt gấp đôi

10:14 - 31/07/2020
“Giải mã” vũ khí gây ung thư của loại vi khuẩn miễn nhiễm axít dạ dày
TNNN - Chỉ cần hoạt hóa thứ vũ khí này ở giai đoạn đầu của quá trình nhiễm trùng cũng đủ để “làm ngòi nổ” cho sự thay đổi của tế bào dạ dày, dẫn đến...